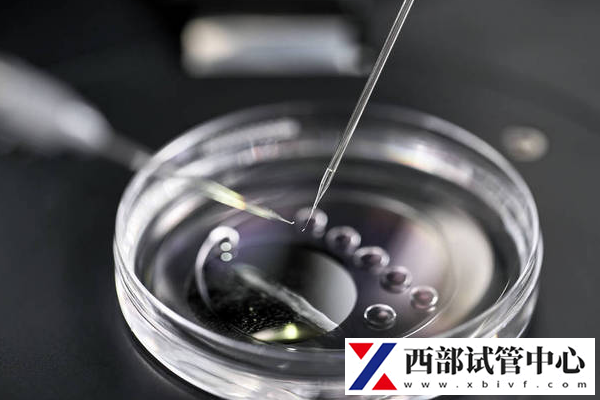
備孕多久不懷孕可以做試管嬰兒

備孕多久不孕才能做試管嬰兒手術(shù)?最新版詳細(xì)解析在這里!
在探討備孕多久后若仍未成功受孕,夫妻們往往會(huì)關(guān)注“不孕多久后才能考慮試管嬰兒手術(shù)”以及“試管嬰兒手術(shù)作為備選方案的時(shí)機(jī)”。這些問(wèn)題牽動(dòng)著眾多渴望成為父母的心,涉及生育路上的重要抉擇。
備孕多久不孕才能做試管嬰兒?
1.做試管要看備孕時(shí)間
通常來(lái)說(shuō),正常備孕未孕1年以上,即可診斷為不孕。而超過(guò)35周歲的高齡女性,正常備孕超過(guò)半年未孕就應(yīng)該到院就診。
所以對(duì)于有生育需求的夫婦,需到生殖醫(yī)學(xué)科進(jìn)行詳細(xì)的檢查和評(píng)估,如確診符合試管適應(yīng)癥,可進(jìn)行試管助孕診療。
注意:不孕不育并不一定就要做試管,但采取什么樣的治療方法,一定要到專業(yè)的醫(yī)院請(qǐng)醫(yī)生指導(dǎo)治療方案。
2.做試管要了解既往病史
在評(píng)估不孕夫婦是否符合試管適應(yīng)癥之前,需要詳細(xì)了解夫妻雙方的既往病史。
對(duì)于既往做過(guò)盆腔手術(shù)的,以及采取監(jiān)測(cè)排卵指導(dǎo)同房等治療方式,或通過(guò)3次人工授精助孕后未孕的人群,都符合試管的適應(yīng)癥。
對(duì)于男方有確診過(guò)精子質(zhì)量方面的疾病,也可以做試管嬰兒。不過(guò)具體能否開(kāi)展,以及需要開(kāi)展哪一種助孕方式,都需要專業(yè)的生殖醫(yī)生來(lái)判斷。

3.試管嬰兒的適應(yīng)癥
試管嬰兒根據(jù)技術(shù)不同,面向的適應(yīng)人群也有差異。
體外受精與胚胎移植(IVF-ET):適應(yīng)人群
1)輸卵管因素:經(jīng)輸卵管造影或腹腔鏡證實(shí)雙側(cè)輸卵管阻塞、積水、結(jié)核或切除,先天性輸卵管發(fā)育不良,嚴(yán)重的盆腔粘連、輸卵管內(nèi)膜受損致配子運(yùn)輸障礙等;
2)排卵因素:頑固性多囊卵巢綜合征(PCOS)經(jīng)反復(fù)促排卵治療或?qū)m腔內(nèi)人工授精未孕;未破裂卵泡黃素化綜合征(LUFS)經(jīng)多次藥物治療或卵泡穿刺未孕;
3)子宮內(nèi)膜異位癥:經(jīng)常規(guī)藥物或手術(shù)治療未孕;
4)男方因素:男性輕、中度的少、弱、畸精癥,經(jīng)多次宮腔內(nèi)人工授精未孕;
5)不明原因的不孕癥;
6)免疫性不孕癥。
卵胞漿內(nèi)單精子注射技術(shù)(ICSI):適應(yīng)人群
1)嚴(yán)重的少、弱、畸精子癥;
2)不可逆的梗阻性無(wú)精子癥;
3)生精功能障礙(排除遺傳缺陷疾病所致);
4)免疫性不育;
5)體外受精失敗或受精率低;
6)精子頂體異常。
綜上所述,備孕的時(shí)間長(zhǎng)短并不是決定能否進(jìn)行試管嬰兒手術(shù)的唯一因素,還需綜合考慮夫妻雙方的身體健康狀況、年齡以及醫(yī)生的建議。在面對(duì)不孕挑戰(zhàn)時(shí),保持樂(lè)觀心態(tài),積極配合專業(yè)治療,是通往成功育兒之路的關(guān)鍵。





